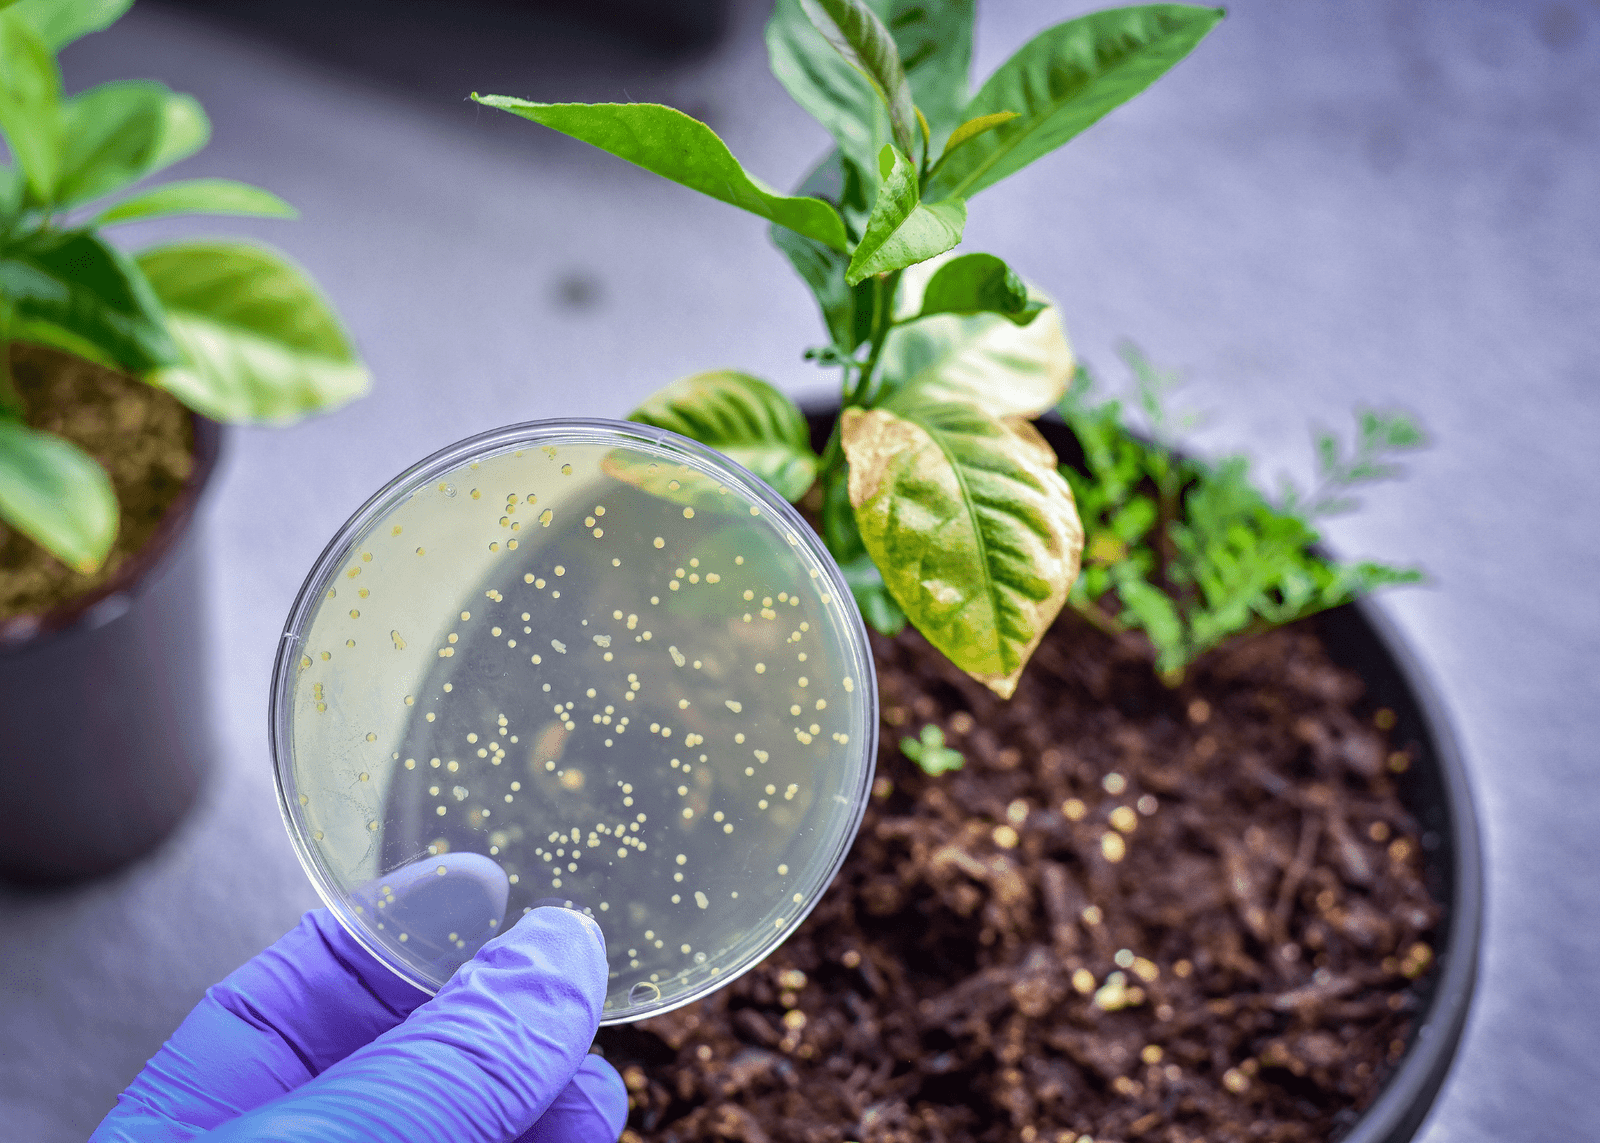
Six Ways Cinnamon Can Support Your Plants' Growth to Enhance Your Garden - ManMadeDIY

Is your Maranta leggy, with more stems than leaves? Here’s How to Grow a Bushier Prayer Plant with a Bounce Like Never Before!
The prayer plant, Maranta leuconeura, captivates with its exquisite, feather-like patterned leaves showing off green and purple hues. However, neglect can lead to a leggy and uninspiring plant. Here’s how to cultivate a fuller, bushier prayer plant.

Sequential Pruning Pinching
While prayer plants don’t demand frequent pruning, strategic trimming can manage wild growth. Sequential pruning involves gradually cutting back the plant in phases, section by section, to minimize stress.
Pruning above the nodes and removing any damaged leaves encourages a bushier form. Allow sufficient recovery time between pruning sessions. Employ clean, sharp shears making precise cuts just above leaf nodes to encourage lateral shoots.
Pinching off new growth tips also stimulates branching for a more filled-out appearance. Conduct pruning during the growing season, typically spring and summer, for faster healing.

Rotate your Potted Prayer Plant
If your Maranta is developing unevenly, exhibiting lush growth on one side and sparse growth on the other, it usually indicates unbalanced light exposure. The side exposed to greater light tends to flourish more. It’s a common occurence for plants to grow toward light.
Rotate your plant container a quarter turn every one to two weeks. Continuous rotation will distribute sunlight equally across the plant, fostering a vigorous, bushy appearance.
:max_bytes(150000):strip_icc()/SPR-grow-calathea-indoors-1902745-hero-ec9ad66c01b74dca97ea02e167b6a660.jpg)
Marantas Can Get Sun-Burn!
Although prayer plants require even light exposure, their fragile leaves are susceptible to sunburn from direct sunlight. Position your potted plant in a location receiving bright, indirect light – perhaps an east-facing window – to support healthy foliage growth.
Tip: Distance the plant from exceptionally bright windows or use sheer window coverings to diffuse the light.
Prayer Plants like it Cozy
Prayer plants thrive in a humidity range of 50-60%. In environments lacking sufficient moisture, use a humidifier or place the pot on a tray filled with pebbles and water.
Other options include regular misting or placing the plant in humid areas such as bathrooms or kitchens. Grouping it with other humidity-loving plants such as ferns, calatheas, or orchids can also help.
Tip: Grouping plants together increases humidity levels, creating a lush, indoor jungle ambiance.

Repot in Wider Containers
Prayer plants initially require a container at least six inches in diameter, and larger as they grow. Due to their natural trailing habit, repot them into wider containers -at least eight inches across- to facilitate outward growth.
A wider pot encourages lateral expansion rather than upward growth, resulting in shorter stems and abundant leaves.
Tip: When selecting a slightly wider pot, ensure it remains shallow. Deep, slender pots can trap excess moisture and cause root rot.

Cinnamon Water Spray
Cinnamon serves many functions, including keeping fungal infections and molds at bay, supporting healthy prayer plant growth. Some even suggest that it has growth-stimulating compounds that help the plant stay healthy and bushy.
Mix one teaspoon of cinnamon powder into one quart of water or boil a cinnamon stick in water. Allow the mixture to settle for 60 minutes, then strain and pour into a spray bottle. Lightly mist the plant to prevent fungal problems and improve root health. Use sparingly to prevent soil disruption.
A Dose of Epsom Salt
During the growing season, add a small amount of Epsom salt to the water when watering your prayer plant about once a month. Magnesium supports photosynthesis and overall plant health, promoting stronger, bushier growth.
Dissolve approximately half a teaspoon of Epsom salt in a gallon of water for regular watering. Avoid overuse to prevent salt accumulation in the soil.

Boost Rhizome Growth with Light Tilling
Prayer plants propagate via rhizomes, or underground stems that naturally produce new shoots. Improving the development of these rhizomes can increase growth and create a bushier plant.
Gently loosen the surface layer of soil to facilitate rhizome spread; exercise caution to avoid root damage.
Apply a top dressing of compost or organic matter to provide nutrients and encourage the production of healthy shoots. Maintain consistent soil moisture levels, but do not overwater.

Encourage Lateral Growth
Because prayer plants naturally spread laterally, training their long stems across the soil surface will stimulate new shoots, increasing density to make your plant look bushier and fuller. Use small U-shaped clips to gently pin down the stems, encouraging them to sprawl outward.
Ensure the nodes—the points where leaves emerge—are in contact with the soil. Roots will emerge from these nodes, contributing to new growth, resulting in a fuller, bushier prayer plant than ever before.

Conclusion
In summary, cultivating a bushier Maranta involves a multifaceted approach that integrates strategic sequential pruning, even light exposure through regular rotation, and careful positioning away from direct sunlight to prevent leaf burn. Providing the right humidity levels, repotting in wider containers, and employing natural remedies like cinnamon water and Epsom salt can further enhance growth and health. Lastly, encouraging lateral growth through light tilling and fixing the stems to the soil helps in achieving a denser plant structure. By implementing these techniques consistently, you can transform your leggy prayer plant into a vibrant and thriving specimen, showcasing its beautiful foliage to the fullest.

